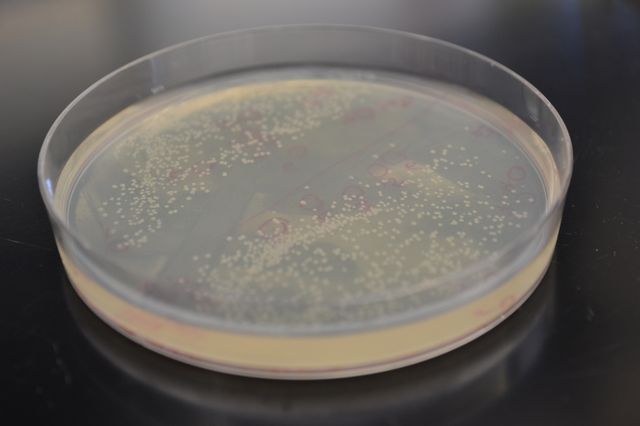
Synthetic metabolic pathway

UCLA chemical engineering researchers have created a new synthetic metabolic pathway for breaking down glucose that could lead to a 50 percent increase in the production of biofuels.
The new pathway is intended to replace the natural metabolic pathway known as glycolysis, a series of chemical reactions that nearly all organisms use to convert sugars into the molecular precursors that cells need. Glycolysis converts four of the six carbon atoms found in glucose into two-carbon molecules known acetyl-CoA, a precursor to biofuels like ethanol and butanol, as well as fatty acids, amino acids and pharmaceuticals. However, the two remaining glucose carbons are lost as carbon dioxide.
Glycolysis is currently used in biorefinies to convert sugars derived from plant biomass into biofuels, but the loss of two carbon atoms for every six that are input is seen as a major gap in the efficiency of the process. The UCLA research team's synthetic glycolytic pathway converts all six glucose carbon atoms into three molecules of acetyl-CoA without losing any as carbon dioxide.
The paper's other author is Tzu-Shyang Lin, who recently received a bachelor's degree from UCLA in chemical engineering.
The research is published online Sept. 29 in the peer-reviewed journal Nature.
The principal investigator on the research is James Liao, UCLA's Ralph M. Parsons Foundation Professor of Chemical Engineering and chair of the chemical and biomolecular engineering department. Igor Bogorad, a graduate student in Liao's laboratory, is the lead author.
"This pathway solved one of the most significant limitations in biofuel production and biorefining: losing one-third of carbon from carbohydrate raw materials," Liao said. "This limitation was previously thought to be insurmountable because of the way glycolysis evolved."
The principal investigator on the research is James Liao, UCLA's Ralph M. Parsons Foundation Professor of Chemical Engineering and chair of the chemical and biomolecular engineering department. Igor Bogorad, a graduate student in Liao's laboratory, is the lead author.
"This pathway solved one of the most significant limitations in biofuel production and biorefining: losing one-third of carbon from carbohydrate raw materials," Liao said. "This limitation was previously thought to be insurmountable because of the way glycolysis evolved."
This synthetic pathway uses enzymes found in several distinct pathways in nature.
The team first tested and confirmed that the new pathway worked in vitro. Then, they genetically engineered E. coli bacteria to use the synthetic pathway and demonstrated complete carbon conservation. The resulting acetyl-CoA molecules can be used to produce a desired chemical with higher carbon efficiency. The researchers dubbed their new hybrid pathway non-oxidative glycolysis, or NOG.
"This is a fundamentally new cycle," Bogorad said. "We rerouted the most central metabolic pathway and found a way to increase the production of acetyl-CoA. Instead of losing carbon atoms to CO2, you can now conserve them and improve your yields and produce even more product."
"This is a fundamentally new cycle," Bogorad said. "We rerouted the most central metabolic pathway and found a way to increase the production of acetyl-CoA. Instead of losing carbon atoms to CO2, you can now conserve them and improve your yields and produce even more product."
The researchers also noted that this new synthetic pathway could be used with many kinds of sugars, which in each case have different numbers of carbon atoms per molecule, and no carbon would be wasted.
"For biorefining, a 50 percent improvement in yield would be a huge increase," Bogorad said. "NOG can be a nice platform with different sugars for a 100 percent conversion to acetyl-CoA. We envision that NOG will have wide-reaching applications and will open up many new possibilities because of the way we can conserve carbon."
The researchers also suggest this new pathway could be used in biofuel production using photosynthetic microbes.
"For biorefining, a 50 percent improvement in yield would be a huge increase," Bogorad said. "NOG can be a nice platform with different sugars for a 100 percent conversion to acetyl-CoA. We envision that NOG will have wide-reaching applications and will open up many new possibilities because of the way we can conserve carbon."
The researchers also suggest this new pathway could be used in biofuel production using photosynthetic microbes.
The paper's other author is Tzu-Shyang Lin, who recently received a bachelor's degree from UCLA in chemical engineering.
The UCLA Henry Samueli School of Engineering and Applied Science, established in 1945, offers 28 academic and professional degree programs and has an enrollment of more than 5,000 students. The school's distinguished faculty are leading research to address many of the critical challenges of the 21st century, including renewable energy, clean water, health care, wireless sensing and networking, and cyber-security. Ranked among the top 10 engineering schools at public universities nationwide, the school is home to eight multimillion-dollar interdisciplinary research centers in wireless sensor systems, wireless health, nanoelectronics, nanomedicine, renewable energy, customized computing, the smart grid, and the Internet, all funded by federal and private agencies and individual donors.
For more news, visit the UCLA Newsroom and follow us on Twitter.